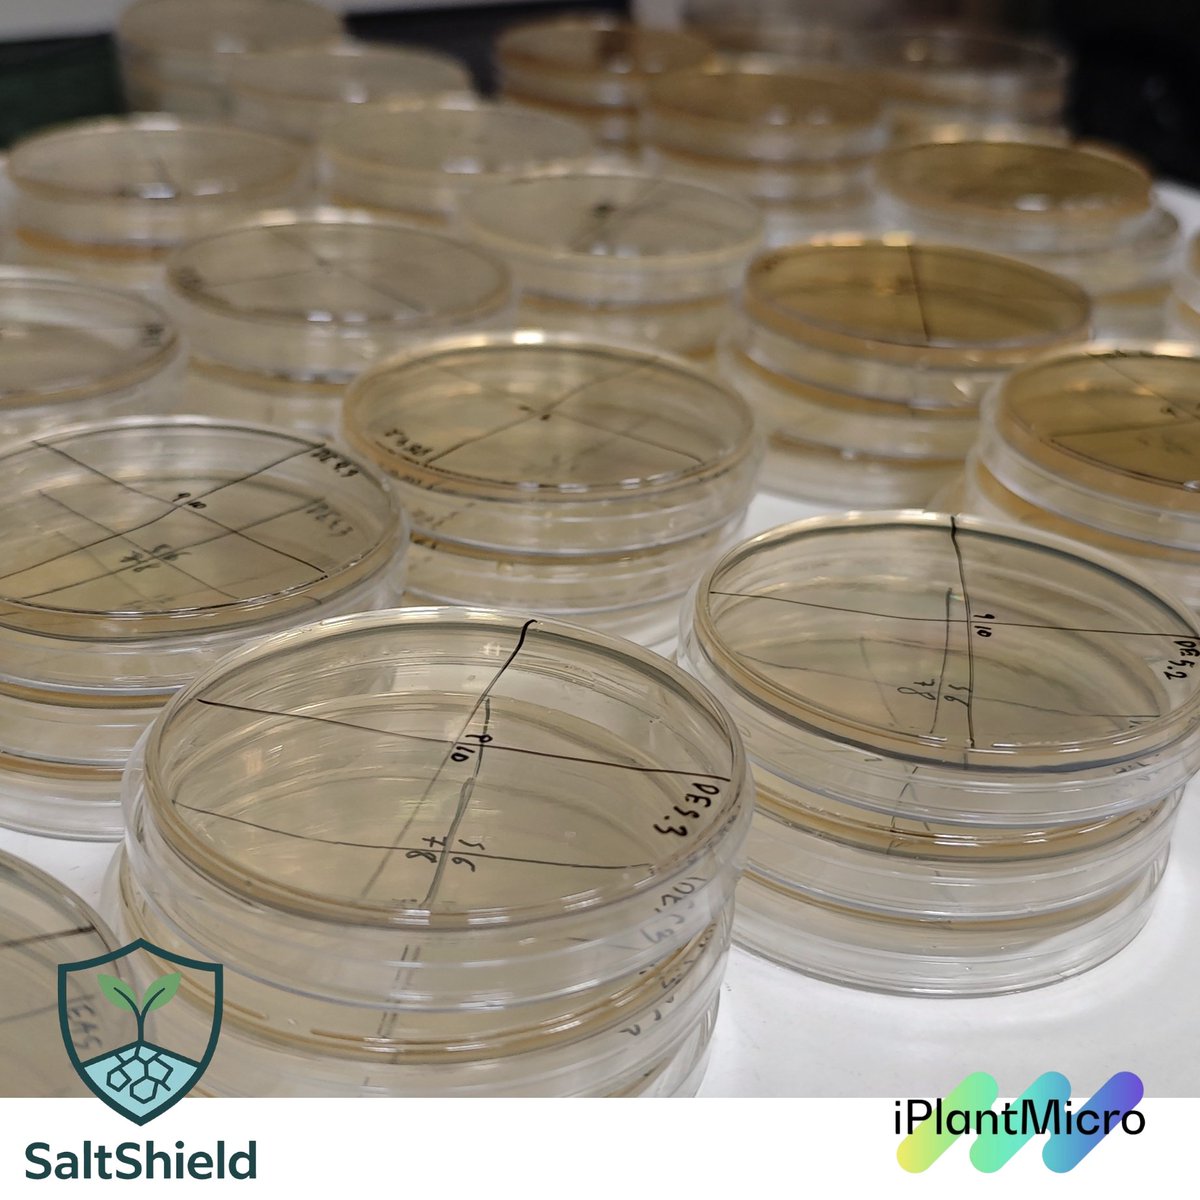
iPlantMicro Lab tweet media
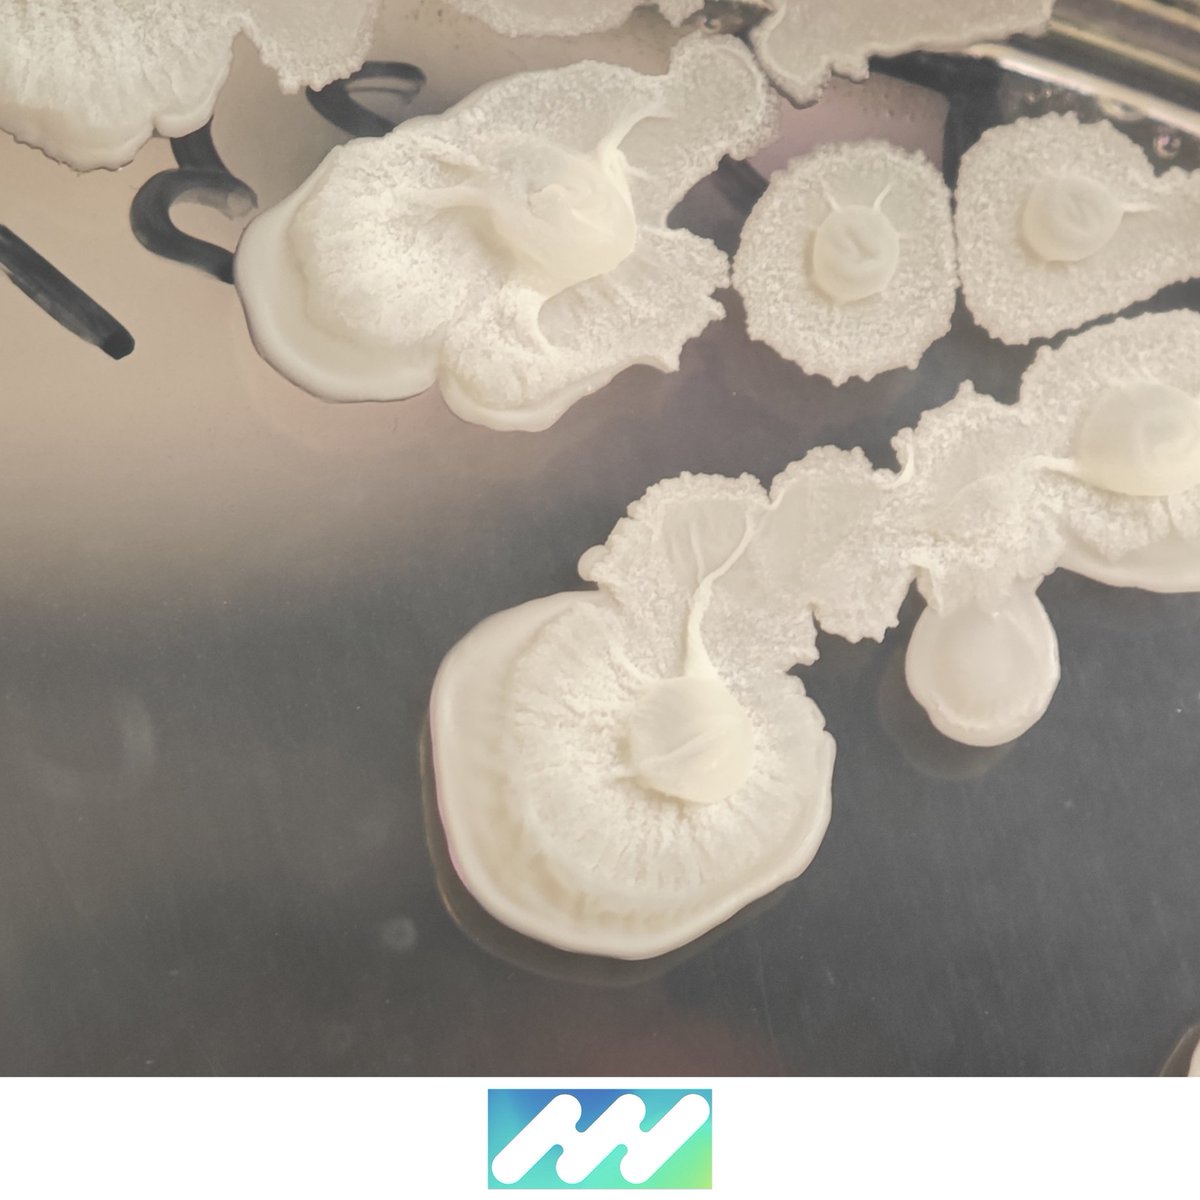
iPlantMicro Lab tweet media

Last week, with zero planning, most of the lab fell into the culture-verse 🧫
Watching everyone struggle to count colonies and debate if this was a new morphotype or just the same creamy-transparent thing 🤣
Oddly… kind of therapeutic?
@itqbnova
@greenit_bio4sus




English